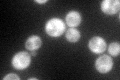
YHR170W
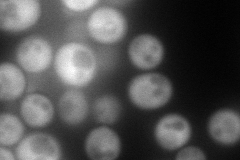
YHR170W
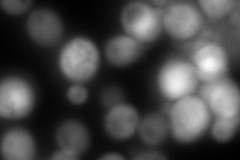
YHR170W
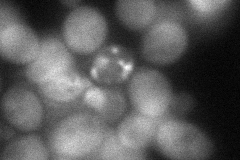
YHR170W
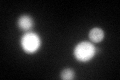
YHR170W
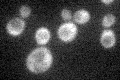
YHR170W

View description
Protein involved in nuclear export of the large ribosomal subunit; acts as a Crm1p-dependent adapter protein for export of nascent ribosomal subunits through the nuclear pore complex
Localization:
Intensity:
Fold change:
Significance:
-
C’ GFP library in SD
cytosol91.44 -
N' NOP1pr-GFP in SD
cytosol159.685 -
N' TEF2pr-mCherry in SD
cytosol28.7226 -
N' NATIVEpr-GFP in SD

cytosol66.7678 -
N' TEF2pr-VC and Cyto-VN in SD
cytosol64.1316 -
C’ GFP library in SD+DTT
cytosol79.40.86No -
C’ GFP library in SD+H2O2

cytosol77.470.84No -
C’ GFP library in Starvation Media
cytosolN/AN/AYes -
C’ GFP library on the background of Pup2-DaMP

N/A -
C’ GFP library on the background of CCT mutant

N/A0N/AYes
